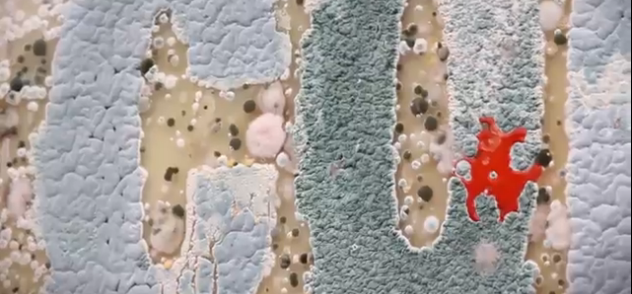

Le dernier film de Soderbergh, très attendu, avec un casting de rêve (dont notre marianne du cinéma, Marion Cotillard) est sorti aujourd’hui au Canada.
Pour créer du buzz et promouvoir le film, un affichage viral a été mis en place à Toronto. Mais viral dans le sens propre du terme puisqu’en mélangeant science et communication, l’affiche évolue au fil du temps pour devenir très bactérienne…. Et cela se termine par une interprétation artistique de la contagion. Impressionnant ! Notez qu’en France, il faudra attendre le 19 novembre pour être témoin de la contagion. Patience, donc.